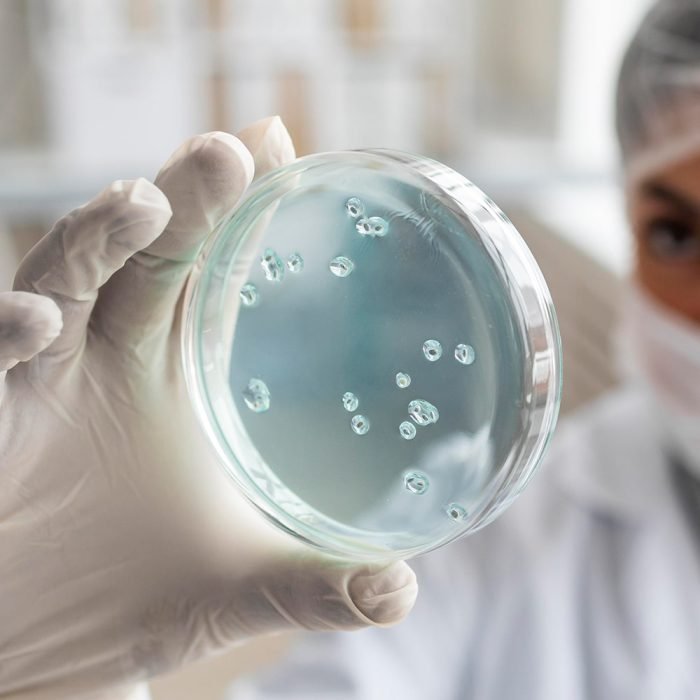
services-img

Better For You
Experiment With Best Lab Products
- Complete Blood Count
- Blood Sugar-Fasting
- post prandial
- Liver Function Test
- Report Efficiency
- Liver Function Test
- Our Equipment
- Best Lab Product
Our Services
High Quality Test Services
WHY CHOOSE US
Provides the Best Experience
Biochemistry Test
Histopathology Test
Microbiology Test
Paternity Testing
Genetic Testing
Chemical Research
Book Your Test
Get Health checkup packages online

PRICING PLANE
Our Suitable Pricing Plan
basic plan
Basic Care
$29/ Per Person
- Complete Blood Count
- Liver Function Blood Test
- Heart Disease Blood Tests
- Cholesterol / Lipid Levels
- Sexually Transmitted Diseases
premium plan
Essential Care
$49/ Per Person
- Sexually Transmitted Diseases
- Cholesterol / Lipid Levels
- Complete Blood Count
- Heart Disease Blood Tests
- Liver Function Blood Test
standard plan
Total Care
$99/ Per Person
- Cholesterol / Lipid Levels
- Sexually Transmitted Diseases
- Complete Blood Count
- Liver Function Blood Test
- Heart Disease Blood Tests

Simon Amour
TECHNICAL DIRECTORAt vero eos et accusamus et iusto odio dignissimos ducimus qui blanditiis praesentium voluptatum deleniti atque corrupti quos dolores et quas molestias excepturi sint occaecati cupiditate non provident, similique sunt in culpa qui officia.

Emma Aria
SENIOR TECHNICIANAt vero eos et accusamus et iusto odio dignissimos ducimus qui blanditiis praesentium voluptatum deleniti atque corrupti quos dolores et quas molestias excepturi sint occaecati cupiditate non provident, similique sunt in culpa qui officia.

Simon Amour
Technical DirectorAt vero eos et accusamus et iusto odio dignissimos ducimus qui blanditiis praesentium voluptatum deleniti atque corrupti quos dolores et quas molestias excepturi sint occaecati cupiditate non provident, similique sunt in culpa qui officia.

Lopes Mads
GENETIC SPECIALISTAt vero eos et accusamus et iusto odio dignissimos ducimus qui blanditiis praesentium voluptatum deleniti atque corrupti quos dolores et quas molestias excepturi sint occaecati cupiditate non provident, similique sunt in culpa qui officia.